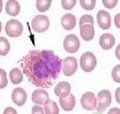
嗜酸細胞增多性復發性肉芽腫皮炎 嗜酸細胞增多性復發性肉芽腫皮炎

病因
可能為一種過敏反應。大多數患者原因完全不明,有些則與節肢動物叮咬,藥物過敏,寄生蟲感染,先天過敏性體質,內臟惡性腫瘤皮膚真菌感染有關。
臨床表現
為反覆發作的大片水腫性紅斑,類似急性蜂窩織炎,數天后形成無痛性、浸潤性肉芽腫性真皮內和皮下組織腫塊,典型皮損位於背上部、四肢或臀部。皮損進展時患部變硬。可在2月內完全消退。全身症狀可有發熱哮喘及關節痛。大多數患者末梢血中嗜酸性粒細胞增高。
診斷
根據臨床表現,皮損特點,組織病理特徵性即可診斷。
檢查
細胞病理:早期真皮內可見緻密的以嗜酸性粒細胞為主的浸潤其中許多嗜酸性粒細胞呈現脫顆粒,浸潤可擴展到皮下組織,甚至可累及其下的肌肉肉芽腫期皮損,嗜酸性粒細胞可見廣泛的脫顆粒在膠原纖維上有鮮紅色顆粒聚集,形成特徵性的“火焰狀圖”(Flame figure)。有些纖維周圍除嗜酸性粒細胞外,可見巨噬細胞和巨細胞呈柵欄狀包繞其中心可形成漸時性壞死。
治療
皮損可自行消退可試用羥嗪(hydroxyzine)和潑尼松治療,亦可試用氨苯碸治療。
預後
皮損進展時患部變硬。可在2月內完全消退。